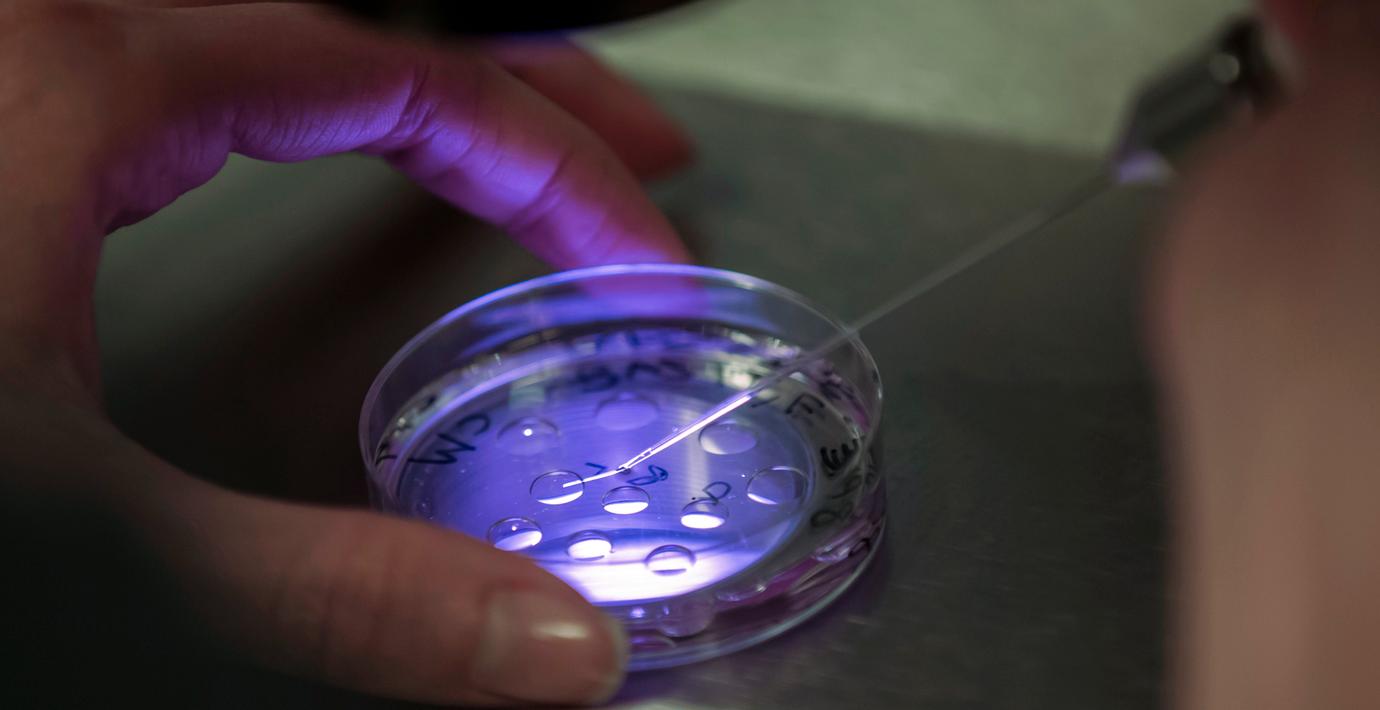

Bolag satsar på boom för kinesisk fertilitetsturism
Sedan Kina lättade på ettbarnspolitiken och numera tillåter kinesiska föräldrar att få två barn har efterfrågan på fertilitetstjänster skjutit i höjden. Det ska landets största resebolag, Ctrip, nu slå mynt av genom en investering i det Shanghaibaserade bolaget IVF USA som erbjuder resor till amerikanska fertilitetskliniker som erbjuder provrörsbefruktning, skriver Caixin. Hur stor investeringen är framgår inte av Caixins rapportering.
bakgrund
Provrörsbefruktning
Wikipedia (sv)
In vitro-fertilisering (IVF) eller provrörsbefruktning är en fertilitetsmetod där kvinnans ägg befruktas av mannens spermier utanför kvinnans kropp (in vitro), i stället för i äggledarna, som efter ett samlag eller vid inseminering. IVF kan utökas med ett flertal metoder. Den vanligaste innebär att spermier och ägg sätts i en droppe näringslösning för att en spermie ska kunna befrukta ett ägg på "naturlig väg", det vill säga som annars skulle ske i kvinnans äggledare. För att ge möjlighet till biologiska barn även för par där spermierna inte lyckas befrukta ägget i näringslösningen har man utvecklat tekniker som bygger på att man med hjälp av en liten glasnål, så kallad mikroinjektion, för in spermien intill eller ända in i äggcellen.
IVF är en metod som ursprungligen mötte mycket kritik för att behandlingen skulle vara oetisk eller att barnen skulle födas med skador.
Omni är politiskt obundna och oberoende. Vi strävar efter att ge fler perspektiv på nyheterna. Har du frågor eller synpunkter kring vår rapportering? Kontakta redaktionen